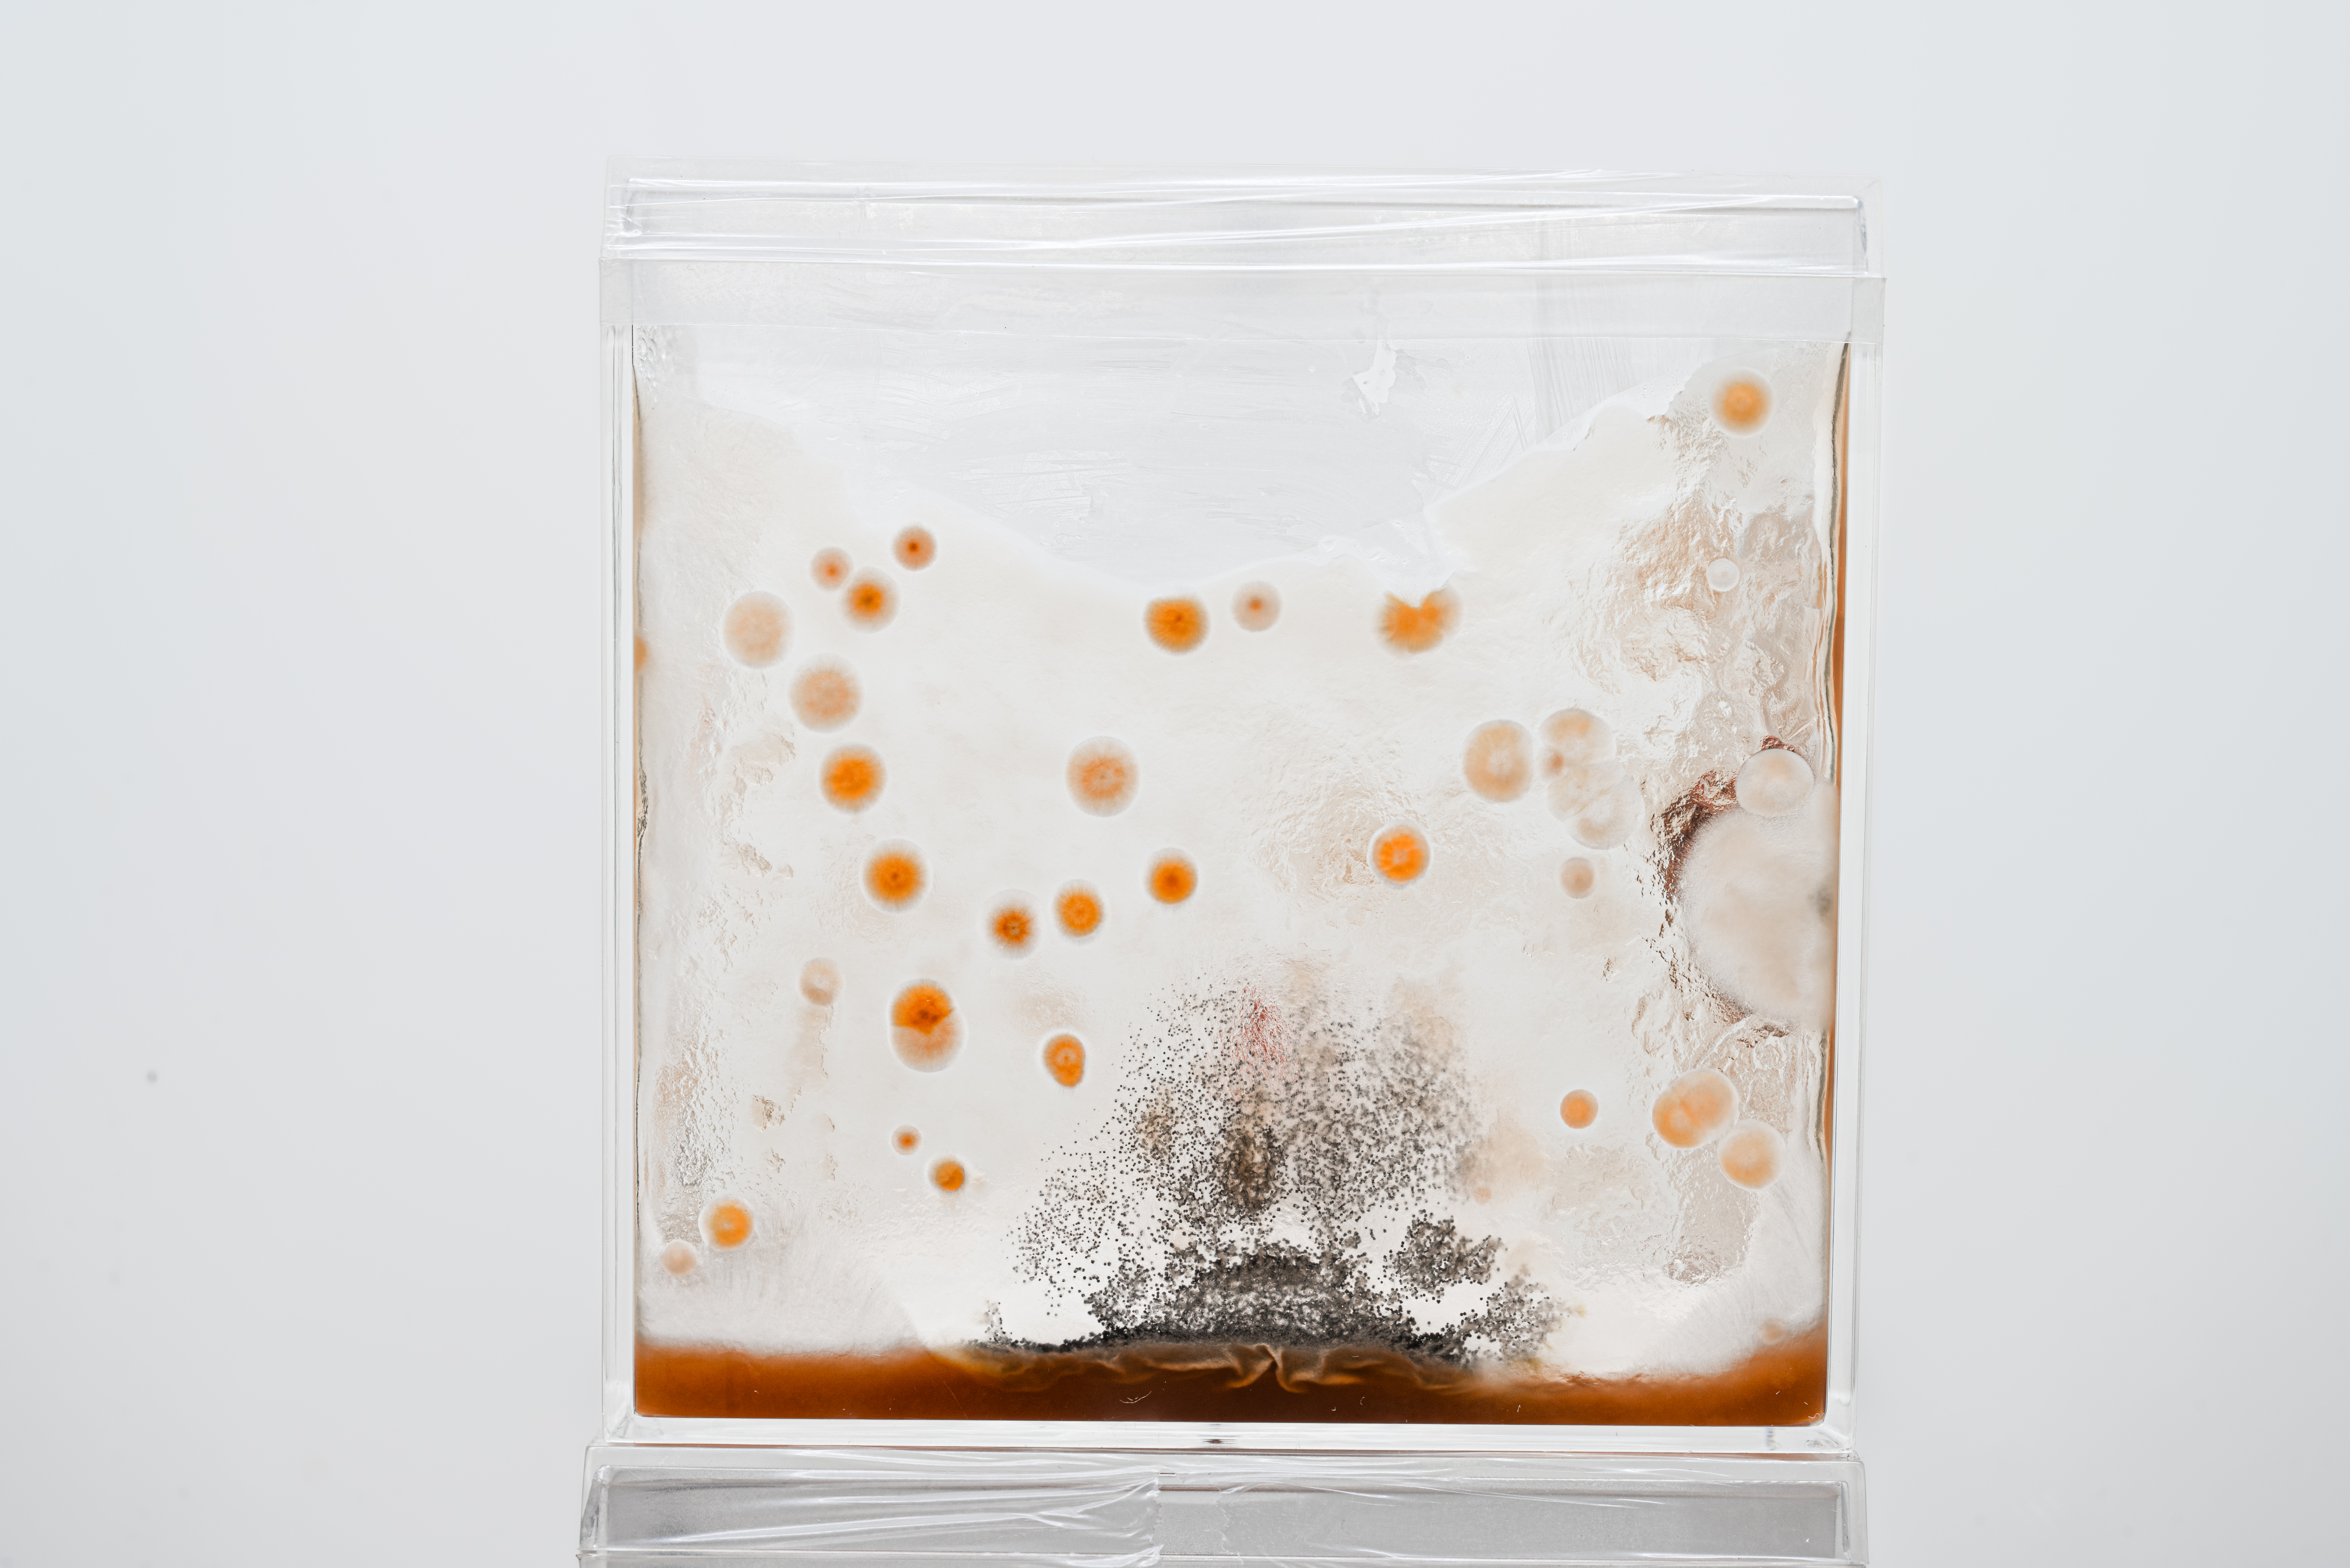

Kara 「殻」#2 - 2025

Title: Kara 「殻」#2
Medium: 3D Installation (UV Print on Lobster Pincer)
Dimensions: 35 x 25.5 x 5 cm(Frame Box), 19.2x 6.5 x 4.3 cm(Left Pincer), 29.4 x 8.8 x 5.2 cm(Right Pincer)
Year: 2025
Medium: 3D Installation (UV Print on Lobster Pincer)
Dimensions: 35 x 25.5 x 5 cm(Frame Box), 19.2x 6.5 x 4.3 cm(Left Pincer), 29.4 x 8.8 x 5.2 cm(Right Pincer)
Year: 2025
Kara 「殻」 Series:
My artistic journey began with a childhood injury—when I was four, I had a severe fracture in my left arm. The surgery left it visibly bent, and this physical trauma became a source of long-term insecurity and bullying. In response, I started projecting myself onto exoskeletal creatures like crabs and lobsters—organisms that can regenerate broken limbs. This fascination with repair and transformation laid the foundation for both of my series, Kara and Mycelial Dialogues.
Inspired by Jane Bennett’s Vibrant Matter, I came to understand the theory of New Materialism, which sees all matter as alive and agentic. This reminds me of the bio-material, the mycelium. I was particularly fascinated by the example of Tokyo’s subway system, originally modeled after the behavior of mycelium navigating toward food across agar. The idea that a nonhuman life form could intuitively map an optimal path captured my imagination.
I began combining mycelium with bones to explore ideas of regrowth and healing. Although I initially aimed to cultivate fully-grown mushrooms, my experiments consistently produced mold instead of fruiting bodies, despite sterile conditions. At first, I viewed this as a failure. But drawing from Junichiro Tanizaki’s In Praise of Shadows, which celebrates imperfection and subtle decay in East Asian aesthetics, I began to see the mold not as contamination but as a poetic metaphor for resilience in ruin. Just like the scar on my arm, the mold became a quiet record of transformation.
Kara 「殻」#1 - 2025

Title: Kara 「殻」#1
Medium: Sound Piece
Year: 2025
Sound Artist: Syan Hu (@aristurtle527)& Tora Zhang (@hvitur_tora)
Throat Singing : Dashen Zhang(@dashshenz)_ dashenzhang.com
Medium: Sound Piece
Year: 2025
Sound Artist: Syan Hu (@aristurtle527)& Tora Zhang (@hvitur_tora)
Throat Singing : Dashen Zhang(@dashshenz)_ dashenzhang.com
Kara 「殻」#0 - 2025



















Title: Kara 「殻」#0
Medium: Photography (Biological Specimen, Mycelium Cultivation)
Year: 2024 - 2025
Mycelial Dialogues 「菌絲對話」 - 2025

Title: Mycelial Dialogues 「菌絲對話」
Medium: 3D Installation (Biological Specimen, Mycelium Cultivation, Photography)
Year: 2024 - 2025
Installation Process & Materials:
Acrylic Box (10 x 10 x 10 cm)
Crab Specimen (Sterilized through Biolab procedures)
Agar Medium as Nutrient Base
Golden Reishi Mycelium Cultivation
Photographic Documentation (Time-Lapse & Static)
Incubation Period: 1 Month
Mustard 「芥子」 - 2023



































Title: Mustard 「芥子karashi」
Medium: Photography with 3D Installation (Biological Specimen, Epoxy Resin)
Year: 2023.
©Syan Hu • Soft Sect Theme by Cargo